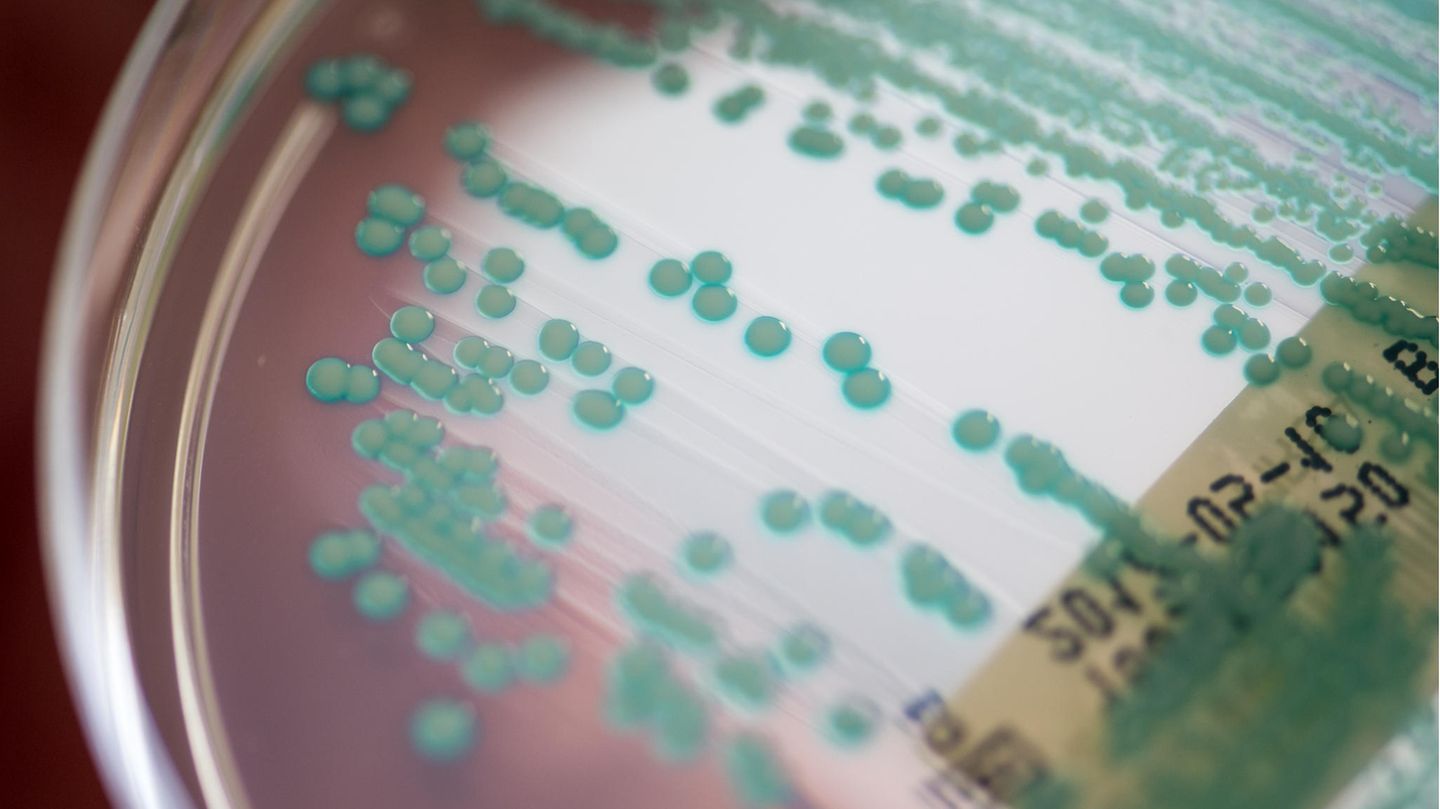

Mehr als 1,2 Millionen Menschen auf der Welt starben 2019 einer Schätzung zufolge unmittelbar an einer Infektion mit einem Antibiotika-resistenten Erreger. Bei fast fünf Millionen Todesfällen war eine solche Infektion demnach mindestens mitverantwortlich für den Tod, berichtet eine internationale Experten-Gruppe im Fachmagazin "The Lancet". Antibiotika-Resistenzen gehörten so gesehen zu den häufigsten Todesursachen weltweit.
Die Forscher hatten für das Jahr 2019 Daten aus der Fachliteratur, aus Krankenhaus-Datenbanken, Überwachungssystemen und anderen Quellen zusammengetragen und diese analysiert. Über statistische Modellierungen prognostizierten die Wissenschaftler die Krankheitslast für verschiedene Regionen, auch für solche, aus denen keine Daten vorlagen.
Es habe bereits zuvor Studien zu einzelnen Regionen, bestimmten Erregern oder einzelnen Antibiotika gegeben. Die nun vorliegende Analyse sei die bisher umfassendste. Insgesamt betrachteten die Forschenden 204 Länder und Regionen, 23 krankmachende Bakterien und 88 Kombinationen von Bakterien und Antibiotika.
Von Antibiotikaresistenz sprechen Ärzte in der Regel, wenn Patienten auf ein Antibiotikum nicht reagieren, das heißt, wenn die krankmachenden Bakterien durch das Antibiotikum – anders als erhofft – nicht vernichtet werden.
4,95 Millionen Todesfälle standen der Studie zufolge in Verbindung mit einer Antibiotika-resistenten bakteriellen Infektion, auch wenn die direkte Todesursache womöglich eine andere war. 1,27 Millionen Menschen starben unmittelbar an einer Infektion mit einem resistenten Bakterium – ohne Resistenzen seien diese Todesfälle also vermeidbar gewesen. Zum Vergleich: An HIV/Aids starben 2020 geschätzt 680 000 Menschen, an Malaria 627 000.
Zu Problemen mit Resistenzen kam es demnach besonders häufig bei Infektionen der unteren Atemwege, also etwa einer Lungenentzündung. Diese allein verursachten 400 000 Todesfälle. Besonders viele Menschen starben auch infolge von Blutvergiftungen und Blinddarmentzündungen, weil die Infektion aufgrund resistenter Erreger mit Antibiotika nicht beherrschbar war.
"Wettlauf gegen die Antibiotika-Resistenz"
Zu den Keimen, die am häufigsten Probleme mit Resistenzen verursachten, gehörten Escherichia coli, Staphylococcus aureus, Klebsiella pneumoniae und Streptococcus pneumoniae. Allein der gefürchtete Krankenhauskeim MRSA – Methicillin-resistenter Staphylococcus aureus – verursachte demnach 100 000 Todesfälle.
Am stärksten betroffen waren der Studie zufolge Länder im westlichen Afrika südlich der Sahara. Dort habe es auf 100 000 Menschen fast 24 Todesfälle gegeben, die sich unmittelbar auf eine Infektion mit einem resistenten Erreger zurückführen ließen. In reichen Ländern lag die Rate bei 13 Todesfällen auf 100 000 Einwohner. Kinder unter fünf Jahren seien am stärksten gefährdet.
"Diese neuen Daten legen das wahre Ausmaß des Problems antimikrobieller Resistenzen weltweit offen und sind ein klares Signal, dass wir jetzt handeln müssen", sagte Mitautor Chris Murray von der University of Washington laut einer Mitteilung des Fachmagazins. "Wir müssen diese Daten nutzen, um den Kurs zu korrigieren und Innovationen voranzutreiben, wenn wir im Wettlauf gegen die Antibiotika-Resistenz die Nase vorn haben wollen."
"Übersehene Pandemie"
Ziel müsse sein, Infektionen weitgehend zu vermeiden durch verbesserte Hygiene oder durch Impfungen. Außerdem müsse der unangemessene Einsatz von Antibiotika – etwa bei viralen Infektionen, die grundsätzlich nicht auf Antibiotika ansprechen – reduziert werden. Neue Antibiotika müssten entwickelt und auf den Markt gebracht werden.
Als Schwächen ihrer Studie nennen die Forscher die begrenzte Datenverfügbarkeit in einigen Teilen der Welt und die unterschiedlichen Quellen für die Daten, die zu Verzerrungen führen können.
Als "übersehene Pandemie" beschreibt Ramanan Laxminarayan vom Center for Disease Dynamics das Problem antibakterieller Resistenzen in einem Kommentar zu der Studie. Obwohl viel mehr Menschen an solchen Infektionen sterben würden als etwa an HIV, flössen weit mehr Spendengelder in die Bekämpfung von HIV und Aids. Das müsse sich ändern. "Von einem unerkannten und versteckten Problem zeichnet sich nun endlich ein klareres Bild der Belastung durch antimikrobielle Resistenzen ab."